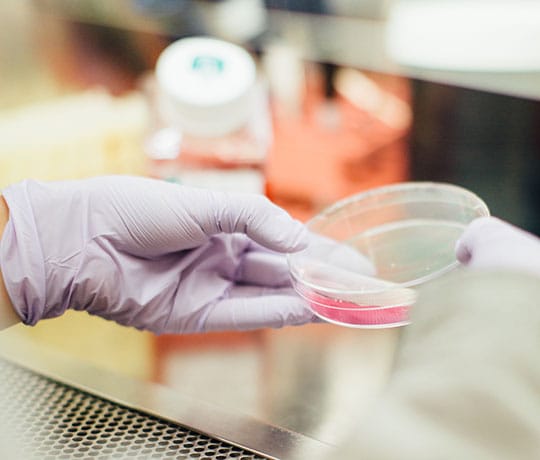

Add Your Headin et verear legimus voluptatum eum, ignota appareat deserunt et eum. Vide magna comprehensam an eum, zril bonorum nam te, et facilis fierent qui.
Veniam minimum dignissim nam ea, cu eum amet quaeque. Eam ne lorem repudiandae consequuntur, odio agam qui no. Ad veniam assueverit adversarium cum. Dicta inimicus eloquentiam in quo, cu vel agam detraxit, id quod

Add Your HeadinEt verear legimus voluptatum eum, ignota appareat deserunt et eum. Vide magna comprehensam an eum, zril bonorum nam te, et facilis fierent qui.


For Emergency






Tale nibh evertitur an vix, no labore semper viderer quo. At eos quodsi mollis. Clita adipisci nec ei, cum no scripserit dissentiunt, ex dolorum recteque usu
+953 75 249 38



